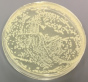

ラインナップ
ノロキンクリア プレミアガード 300mL

ウイルス+菌を99. 99%除去!※1
抗菌効果が約1週間持続※2!従来のアルコールでは
効果の出にくかったウイルスにも効果を発揮
製品詳細
トリプル効果で徹底除菌!
アルコールが揮散した後も「ジェミニ型除菌成分」が処理面に残るので、ウイルス・菌・カビに対する効果が続きます。
抗菌効果が持続するから、菌由来のニオイも予防!
「ジェミニ型除菌成分」とは
「ジェミニ型除菌成分」は、細菌、カビ、酵母、ウイルスに対する効果範囲が広く、pHや温度変化、有機物など除菌効果を妨害する物質の影響を受けにくいので、高い除菌効果を発揮します。また、アルコールと違い、「ジェミニ型除菌成分」は揮散しないので、処理面に残り、除菌効果が持続する点も特長です。
抗菌効果の持続試験
ノロキンクリア プレミアガード
抗菌効果が1週間持続!

アルコール
抗菌効果は持続しません
【試験方法】
ガラス面に「ノロキンクリア プレミアガード」と「アルコール」をスプレーして乾燥させ、それぞれ1週間後に細菌を接種し、細菌の生育の有無を調べた。
石けんやアルコールだけでは効果の出にくい「ノンエンベロープウイルス」に対しても高い効果を発揮。
ノンエンベロープウイルスとは?
エンベロープとは、脂質などからできている膜のことでノンエンベロープウイルスは、この膜を持たないウイルスのことです。ノンエンベロープウイルスは、エンベロープを持つウイルスに比べ、除菌剤が効きにくい傾向があります。

30秒以内に、ウイルス・菌を除去。
「ジェミニ型除菌成分と有機酸とアルコール」のトリプル効果で、高い速効性を発揮します。
塩素不使用なので、有機物(嘔吐物などの汚れ)に対してもすばやく効果を発揮。
また、塩素系消毒剤のようなイヤなニオイや漂白の心配もないので、使用場所を選びません。
※1 すべての菌・ウィルスに効果があるわけではありません。
※2 使用環境により効果は異なります。
使用方法
スプレーの先端を「ON」に合わせて、スプレーする。使用後「OFF」にする。
※引火の恐れがあるので、火気の付近で使用しない。菌やウイルスが気になる場所に直接スプレーする。乾いた布等で拭き取る。あるいは、乾いた布等にスプレーしてから拭き取る。
<まな板、包丁などの調理器具>
スプレーした後、水で洗い流す。
<繊維製品、マスク>
肌に触れない部分にスプレーし、乾燥させる。
※マスク等にスプレーした際に、若干の薬剤臭がする場合がありますが、効果及び安全性については問題ありません。
<使用量の目安>
25×25cmあたり1回スプレー
使用上の注意
応急処置
保管上の注意
使えないもの
水性ワックス・ペンキ・ニス等の塗装部、アクリル・スチロール製のプラスチック、絹・レーヨン等の水に弱い繊維製品、毛皮・革製品、白木や桐の家具、食品
※変色・シミの心配があるものは、あらかじめ目立たないところで試してからご使用ください。